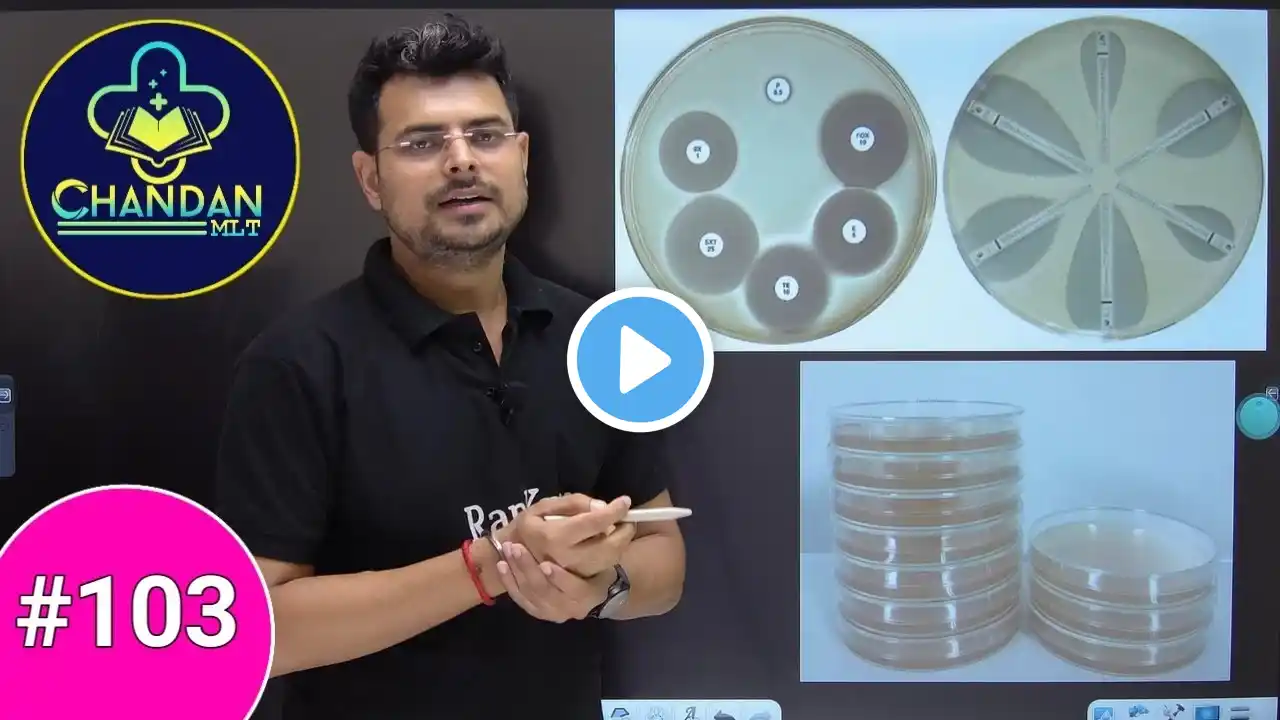
ภาพตัวอย่างวิดีโอ

MCQs class for Lab Technician | Important MCQs for All Lab Technician Exams | Class #88
📱Online courses for Mobile :- https://play.google.com/store/apps/de... 💻Online courses for Computer :- https://rankplusofficial.com/ ➡️What's App Channel Link :- https://whatsapp.com/channel/0029VaAX... 📩Email :- [email protected] 📞Call/What's App :- 91 8235067766 हम (RanKplus) Lab technician प्रतियोगी परीक्षा की तैयारी की कक्षाएं भी संचालित करते हैं, जिसमें निम्नलिखित Exams सम्मिलित है Group 5 Lab Technician, Lab Technologist Exam, RPMC, DRDO, PGIMER, AIIMS CRE, DHA MOH, DSSSB Lab Technician exam, SGPGI, ESIC, RRB paramedical exam, Safdarjung hospital, NHM all state, BPSC Lab technician, Lab Technician, Lab assistant, Lab superintendent classes. ये सभी कक्षाएं आपको लैब तकनीशियन परीक्षा, लैब टेक्नोलॉजिस्ट परीक्षा, लैब सहायक परीक्षा, लैब अधीक्षक परीक्षा, एसजीपीजीआई परीक्षा, पीजीआई चंडीगढ़ (पीजीआईएमईआर), एम्स परीक्षा, आरपीएमएससी परीक्षा आदि में मदद करेंगी। बेहतर तैयारी के लिए आप RanKplus ऐप या हमारी आधिकारिक वेबसाइट पर कक्षाओं में शामिल हो सकते हैं: https://rankplusofficial.com/ Chandan Mlt सर द्वारा प्रदान की गई भारत की सर्वश्रेष्ठ पैरामेडिकल कक्षाएं जिसमें, सभी पैरामेडिकल समाधान प्रदान करते हैं जैसे लाइव कक्षाएं, वीडियो व्याख्यान, पीडीएफ नोट्स, ऑनलाइन टेस्ट श्रृंखला, लैब तकनीशियन परीक्षा के लिए एमसीक्यू वीडियो, एमसीक्यू की पीडीएफ आदि... lab technician mcqs in hindi Lab Technician MCQ - महत्वपूर्ण MCQ Group 5 Lab Technician AIIMS lab technologist class Paramedical online classes Lab Technician महत्वपूर्ण MCQ in hindi lab technicain important mcqs Lab Technician MCQ'S Class For Competitive Exam bmlt classes dmlt online classes TOP 100 MCQ For Lab Technician Exam Lab Technician Exam with this ultimate guide featuring the Top 10 Multiple Choice Questions Lab Technician Live MCQ Class #78 RRB, Group 5, AIIMS CRE , KGMU, BIHAR LT, NHM, ICMR classes MCQ's For Lab technician exam DMLT classes mlt online class AIIMS CRE-4 Lab Technician MCQ Class RRB Paramedical anatomy mcqs classes physiology mcq's classes #labtechnicianclasses #labtechnician #labtechniciancourse #labtechnicianmcqs #labtechnologist #bmltclasses #mltclasses #dmltclasses #chandanmltclasses #rankplusonlineclasses #mcqsforlabtechnicianexam #mcqs #groups5mcqsclasses #nhmlabtechnicain #aiimccremcqs #labassistant #dmlt_video #dmlt_lecture #bmlt_classes #mltians #healthcare #laboratorytechnician #laboratorytechnologist #laboratory #hospital